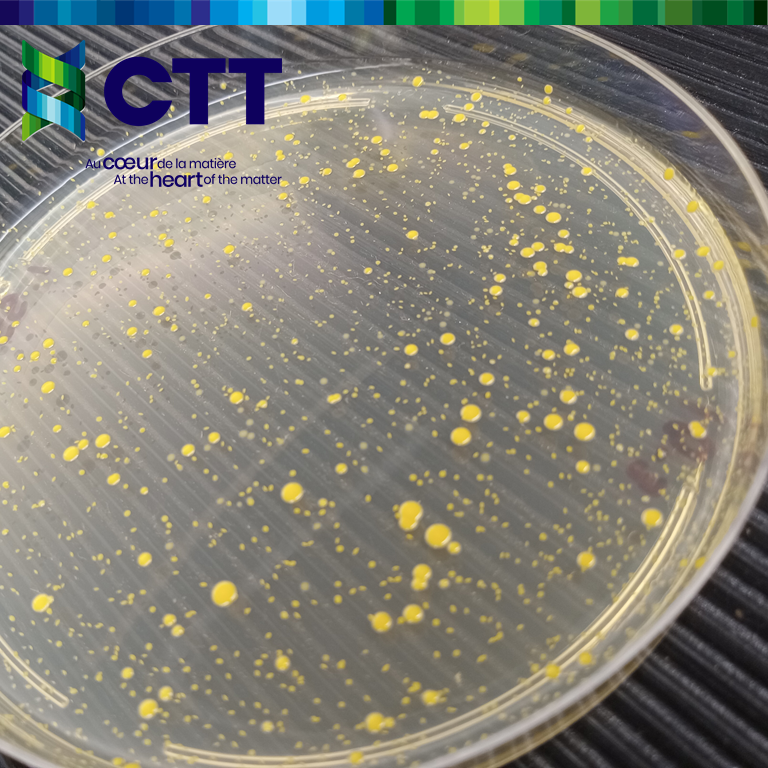
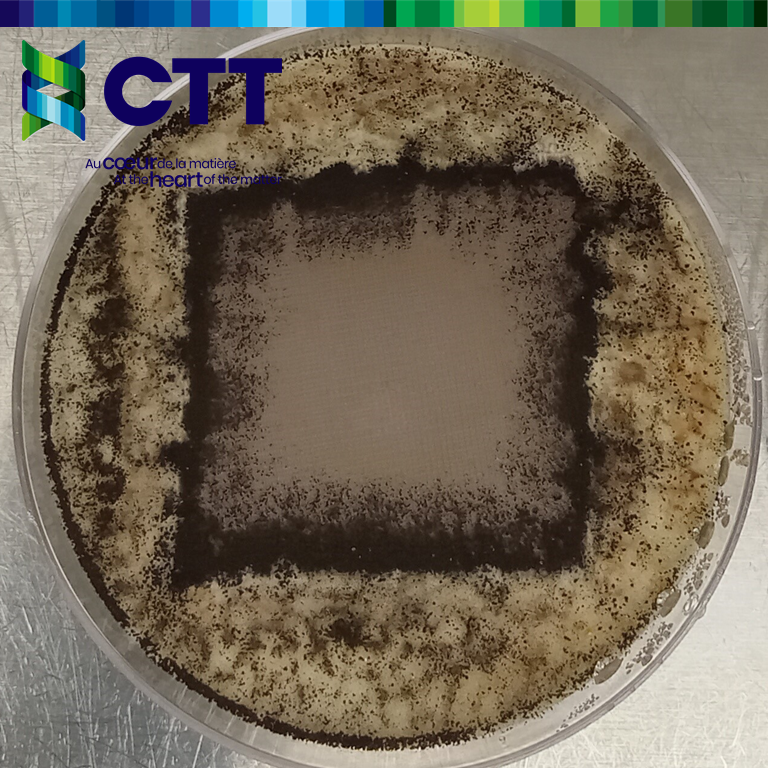

Microbiologie
Services Techniques
Microbiologie | Services Techniques
L’évaluation de la performance des matériaux textiles et polymériques face aux agents microbiologiques permet de déterminer leurs potentiels d’application pour des articles de sport, le domaine médical ou encore la protection et la défense. Les agents tels que bactéries, moisissures, champignons et bactériophages sont utilisés par de nombreuses méthodes d’essai. Ce laboratoire comprend aussi la capacité de biodégradation des matériaux textiles et polymériques.

niveau de confinement 2
Laboratoire contrôlé, niveau de confinement 2, Groupe CTT réalise des tests normalisés pour textiles antimicrobiens et antifongiques : essais de performance et de comportement des textiles, finition textiles, polymères, géosynthétiques lorsqu’exposés à des bactéries, champignons, moisissures et bactériophages.
Les besoins concernent de nombreux secteurs d’application des matériaux textile ou géosynthétiques :
PROPRIÉTÉS ANTIBACTÉRIENNES
Les traitements antibactériens sur textiles peuvent se diviser en deux catégories :
- les traitements bactéricides, ayant un effet léthal pour les bactéries présentes sur le textile, et;
- les traitements bactériostatiques, inhibant la croissance de bactéries.
De nombreux tests existent pour évaluer l’efficacité antibactérienne des textiles, ayant chacun un objectif particulier :
- La charge biologique (« bioburden ») des textiles, représentant la quantité de contamination microbiologique s’évalue suivant la méthode standard ISO 11737-1. L’évaluation des microorganismes se fait par observation visuelle nécessitant les compétences en microbiologie.
- Pour observer visuellement l’activité bactériostatique d’un textile, on utilise AATCC 147. Cette méthode consiste à inoculer 5 stries d’une culture bactérienne sur une gélose et déposer par-dessus le textile à tester. Après une période d’incubation de 24h la gélose et l’échantillon sont observés pour évaluer s’il y a inhibition sous l’échantillon et autour de celui-ci.
- L’activité bactéricide peut être évaluée suivant AATCC 100, ou encore ISO 20743. Une concentration connue de culture bactérienne est déposée sur l’échantillon textile. Après une période d’incubation de 24heures, un comptage des colonies bactériennes est effectué afin de déterminer le pourcentage de réduction des bactéries. Des prélèvements se font à des intervalles de temps prédéterminés, en accord avec le client. Ceci permet de déterminer le pourcentage de réduction à des temps de contact textile-bactéries fixes, comme par exemple, après 5 minutes, 1h ou 24h de contact. D’autres temps de contact sont disponibles sur simple demande.
- La méthode AATCC 211 est spécifiquement dédiée à l’évaluation des performances textiles pour le contrôle des odeurs des textiles traités avec des antibactériens.
Des bactéries standard sont utilisées pour chacun de ces essais, bien qu’il soit possible de modifier les souches en fonction des besoins particuliers. Quelques exemples de ces bactéries : Staphylococcus aureus, MRSA et Klebsiella pneumoniae, ou encore Proteus vulgaris et Staphylococcus saprophyticus.
PROPRIÉTÉS ANTIFONGIQUES
Les traitements antifongiques permettent aux matériaux un meilleur vieillissement et comportement lorsqu’exposés à des spores de mycètes (champignons et moisissures).
Les méthodes CAN/CGSB 4.2 No 28.2 Résistance aux micro-organismes — Essai par fongus se propageant en surface et AATCC 30 option III, permettent de visualiser l’effet antifongique d’un matériaux textile exposé à la souche Aspergillus Niger. L’échantillon est placé sur un média favorable à la croissance fongique, un échantillon est contaminé par des spores puis placé en incubation pendant plusieurs jours. L’évaluation de la croissance fongique est faite pour la surface de l’échantillon et sur le pourtour du spécimen.
D’autres méthodes en développement utilisent le même principe, avec d’autres souches fongiques :
- CAN/CGSB 4.2 No 28.4 Résistance aux micro-organismes — Évaluation des dommages causés par fongus, utilisé pour les matériaux textiles
- ASTM G21 “Determining Resistance of Synthetic Polymeric Materials to Fungi” principalement pour les enveloppes du bâtiment
- ASTM G160 “Evaluating Microbial Susceptibility of Nonmetallic Materials by Laboratory Soil Burial for materials that are exposed to soil and soil microorganisms, and susceptible to be physically damaged”.
PENETRATION VIRALE
Pour les textiles barrières servant aux Équipements de Protection Individuelle, une méthode largement utilisée consiste à évaluer la résistance à la pénétration virale.
Suivant ASTM F1671, “Resistance of Materials Used in Protective Clothing to Penetration by Blood-Borne Pathogens Using Phi-X174 Bacteriophage Penetration as a Test System”, un bactériophage est utilisé pour évaluer l’efficacité des barrières textiles. Cet essai permet une évaluation de la performance de l’effet barrière après un temps d’exposition au bactériophage.
Quelques spécifications utilisant cette norme d’Essai :
BIODÉGRADABILITÉ ET COMPOSTABILITÉ
Représentant un des axes de recherche en Développement Durable via la Chaire de Recherche Ecotextile, la capacité des matériaux textiles ou polymériques à la biodégradation est évaluée suivant plusieurs méthodes. Les échantillons sont exposés à un inoculum de déchets municipaux dans un environnement à température et humidité contrôlées, durant une période minimale de 15 ou 45 jours et jusqu’à atteindre le palier de dégradation. Le degré de biodégradabilité est enregistré en continu en déterminant le pourcentage de carbone converti en CO2.
ASTM D5338
“Determining Aerobic Biodegradation of Plastic Materials Under Controlled Composting Conditions, Incorporating Thermophilic Temperatures”.
ASTM D5511
“Determining Anaerobic Biodegradation of Plastic Materials Under High-Solids Anaerobic-Digestion Conditions – En cours de développement”.
EXPERTISES ET DÉVELOPPEMENTS
L’expertise du CTT sur le comportement des matériaux textiles et polymériques vis-à-vis des microorganismes permet de réaliser des analyses d’investigation, notamment pour déterminer l’origine d’odeurs ou de tâches ou déterminer si des échantillons sont contaminés par des champignons ou moisissures.
Dans le cadre de ses projets de développement de produits, CTT peut créer des formulations antibactériennes ou antifongiques, selon les besoins de nos clients, pour chacune de leurs applications, et adaptées aux différents marchés.
Voici quelques possibilités et réalisations:
Pour en savoir plus sur les mécanismes antimicrobiens, vous pouvez consulter ce chapitre de livre rédigé par nos experts et collaborateurs:
Ibrahim, Ahmad, Laquerre, Joseph-Émile, Forcier, Patricia, Deregnaucourt Vincent, Decaens, Justine, Vermeersch, Olivier. ‘Antimicrobial Agents for Textiles: Types, Mechanisms and Analysis Standards’. Textiles for Functional Applications, IntechOpen, 22 Dec. 2021. Crossref, doi:10.5772/intechopen.98397.
Liens externes
AAMI : https://www.aami.org/
AATCC : AATCC Home – Recherche textile, méthodes de test et éducation depuis 1921.
ASTM : ASTM International | ASTM
CBRN : Chemical, Biological, Radiological, Nuclear and Explosive (CBRNE) Events – Canada.ca
Chapitre de livre : ‘Antimicrobial Agents for Textiles: Types, Mechanisms and Analysis Standards’
CSA : https://www.csagroup.org/
ISO : https://www.iso.org/
NFPA : https://www.nfpa.org